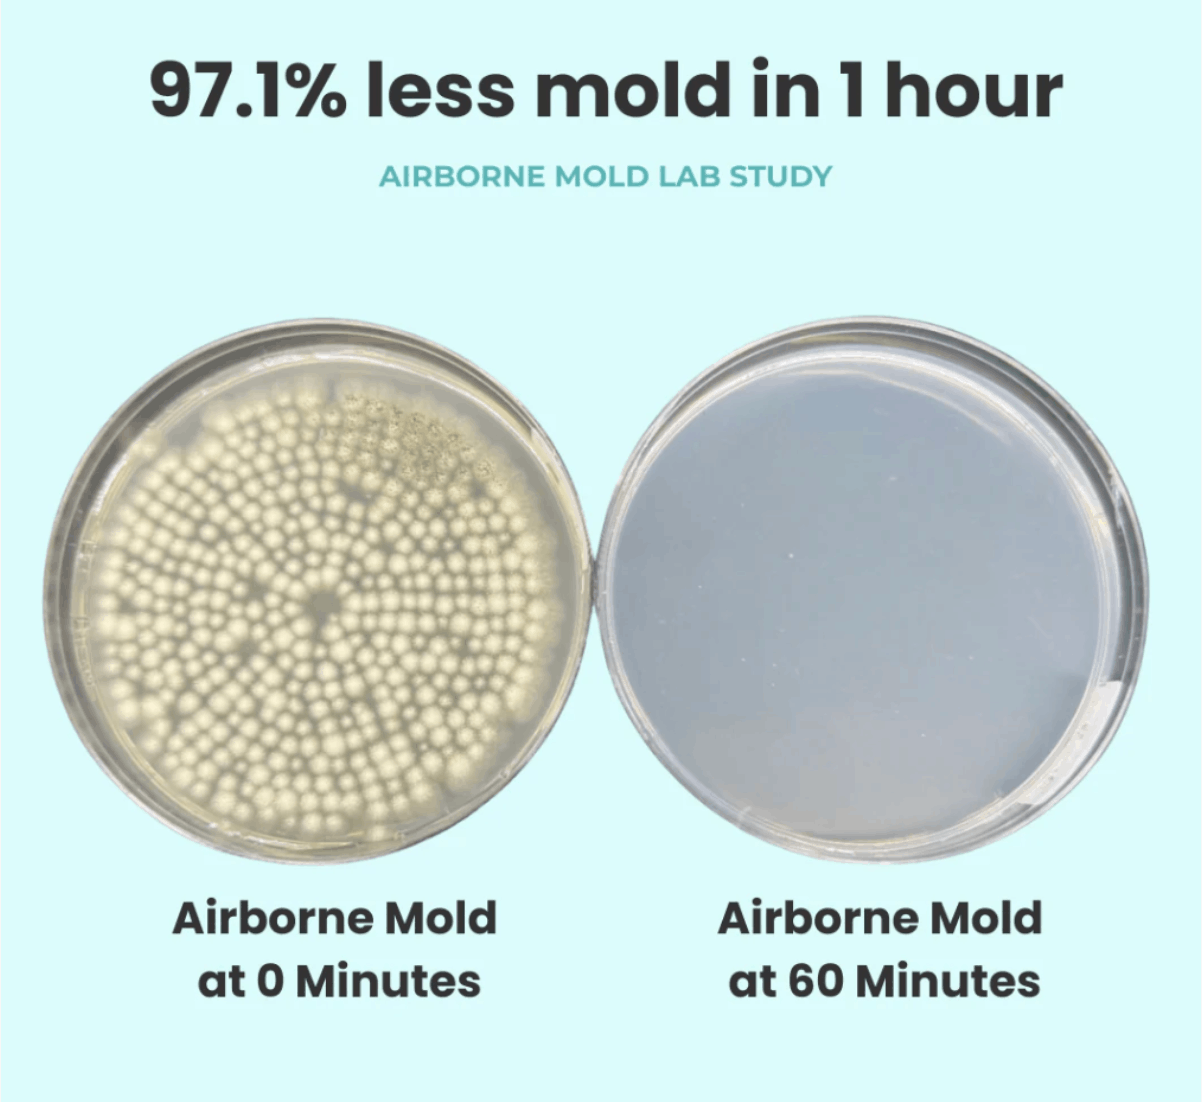

Is Austin’s Air Working Against You?

It’s that time of year again! The bluebonnets are blooming, the weather is almost perfect… and many of our sinuses are… struggling.
If your nose has been running, your eyes are itchy, or you feel like you can’t go anywhere without tissues—we get it. Spring in Austin is beautiful, but it can also be a lot on the body.
Right now, here’s what we’re seeing most in Central Texas:
• Mold spores — elevated after recent rains
• Tree pollens (especially oak, with mulberry and pecan also circulating)
• Fine particulate matter (PM2.5) — higher on windy days
• Grass pollen — ramping up and sticking around for months
• Wind + air particles — moving everything around faster
So that “spring cold” that won’t go away? It’s very likely not a cold at all.
What’s Actually Happening in Your Body
During allergy season, your immune system reacts to harmless environmental particles—like pollen—as if they’re a threat.
This triggers the release of histamine, which leads to symptoms like:
• congestion
• itching
• watery eyes
• inflammation
• skin irritation / rashes
For some people, this response becomes more sensitive over time—especially with repeated exposure or environmental changes (like moving to Austin).
Why OTC Antihistamines Aren't Enough for Austin Allergies
Over-the-counter antihistamines can absolutely help take the edge off symptoms.
At the same time, they tend to work downstream—meaning they help manage the reaction rather than supporting how your body responds over time.
That’s where a more personalized, integrative approach can be helpful!
Allergy Testing + Treatment at West Holistic Medicine
At West Holistic Medicine, we focus on understanding the bigger picture behind your symptoms—not just managing them.
Our FNP-C, Kitty, offers comprehensive allergy testing and personalized treatment plans to help you better understand what your body is responding to.

Here’s what that can look like:
• Targeted allergy testing to identify your specific triggers
• Customized allergy drops (sublingual immunotherapy)
• A long-term approach to support how your body responds over time
• Unrushed visits where you feel heard and supported.

Sublingual immunotherapy (allergy drops) is a well-studied and commonly used approach that works gradually to help your body become less reactive to certain allergens—without the need for weekly injections.
Best Air Purifier for Allergies in Austin — Our Top Pick
You can’t control what’s blooming outside. But you absolutely can control the air inside your home — and this Earth Day, we want to make that easier for you.
We’re proud to partner with Jaspr Air, makers of one of the most effective home air purifiers on the market. Their systems are designed to help reduce airborne particles like dust, pollen, and mold—factors that can quietly impact how you feel day to day.
👉🏼 Use our affiliate link to learn more and save $300
*Discount applied at checkout*
Simple Ways to Support Your Body This Season
A few small shifts can go a long way:
✅ Check pollen counts before heading outside (austinpollen.com is a great resource)
✅ Shower and change clothes after being outdoors
✅ Keep windows closed on high-wind days
✅ Run an air purifier during peak pollen hours (morning + early afternoon)
✅ Focus on anti-inflammatory foods (leafy greens, berries, omega-3s)
✅ Consider testing with Kitty if allergies are a recurring issue for yo
Ready to Feel Better this Spring?
Austin is really beautiful this time of year—the kind of weather that makes you want to be outside, on a walk, at a park, or sitting on a patio.
You should be able to enjoy that without feeling miserable.
If allergies are something you deal with year after year, it may be time to look a little deeper at what your body needs.

🌿 Save $300 on Jaspr Air

Share this article